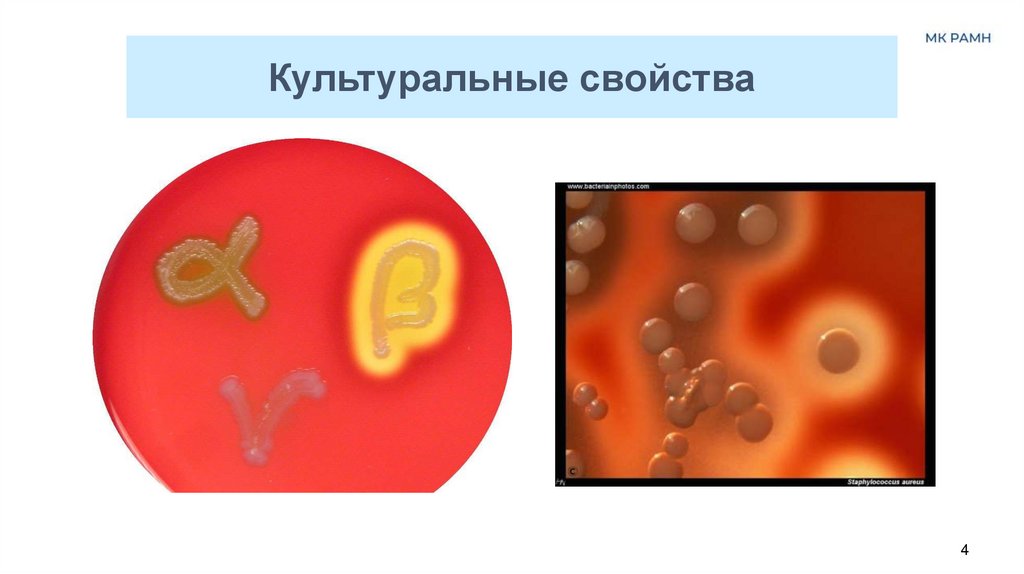
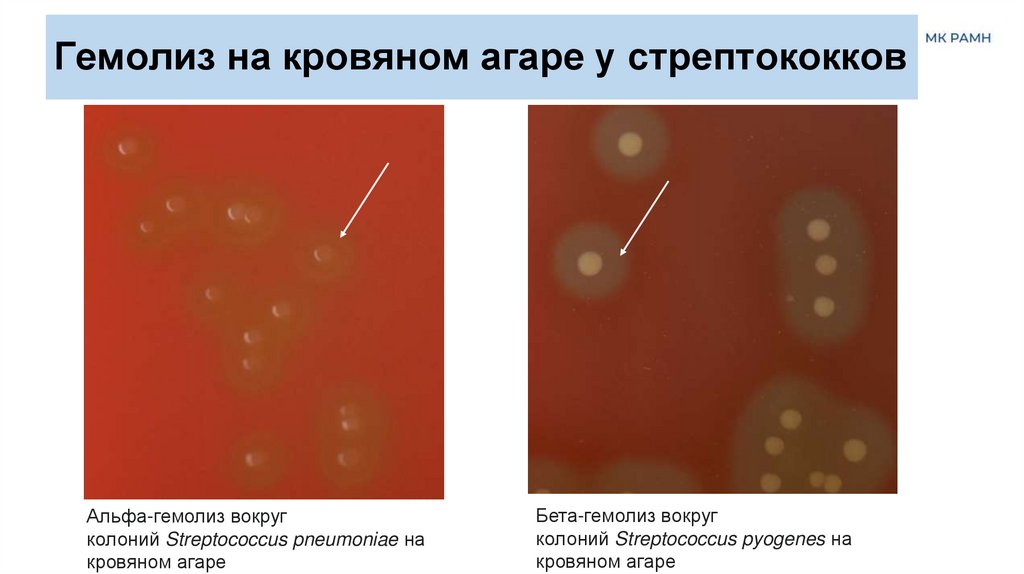

Similar presentations:
Бактерии рода Streptococcus
1.
Возбудители гнойновоспалительныхзаболеваний
Стрептококки
2.
Морфология стрептококков• Грам+ кокки,
• в мазках могут располагаться,
парами (пневмококк),
короткими цепочками (streptosцепочка)
• Спор не образуют, могут
образовывать капсулу,
неподвижные.
2
3.
Культуральные свойства• Факультативные анаэробы,
t - 37o С, время: 18-24 ч., pH:7,2 – 7,6
• Требовательны к питательным средам: рост на
неселективных питательных средах (кровяном агаре или
Колумбийском агаре, сахарном бульоне), на селективных
питательных средах (желчно-эскулиновый агар, бульон с
налидиксовой кислотой и гентамицином)
• На кровяном агаре - колонии мелкие, гладкие, выпуклые с
ровными краями серовато-белые, блестящие, окруженные
зоной гемолиза
По характеру роста на кровяном агаре различают
а-гемолитические стрептококки, окруженные зоной гемолиза с
зеленоватым оттенком,
β-гемолитические, окруженные прозрачной зоной гемолиза и
негемолитические (γ).
• На сахарном бульоне – пристеночный и придонный осадок,
3
4.
Культуральные свойства4
5.
Гемолиз на кровяном агаре у стрептококковАльфа-гемолиз вокруг
колоний Streptococcus pneumoniae на
кровяном агаре
Бета-гемолиз вокруг
колоний Streptococcus pyogenes на
кровяном агаре
6.
Биохимические свойства• Каталаза • Сахаролитические свойства: расщепляют углеводы (глюкозу,
лактозу, мальтозу, сахарозу, маннит иногда и мальтозу) до
кислоты
• Протеолитические свойства слабо выражены: не разжижают
желатин, свертывают молоко
• Образуют ферменты: гиалуронидаза, стрептокиназа
(фибринолизин)
• Образуют токсины: гемолизины (стрептолизин О, разрушает
эритроциты), лейкоцидин (разрушает лейкоциты), эритрогенный
токсин (скарлатинозный) вызывает интоксикацию, сосудистую
реакцию,сыпь, цитотоксины (вызывает гломерулонефрит)
6
7.
Антигенные свойства• Типовые протеиновые антигены - на поверхности
клеточной стенки
• Групповой полисахаридный антиген – в клеточной
стенке (классификация Лэнсфилда: по составу
полисахаридных фракций все стрептококки делятся
на группы А, В,С,D и др.)
• Видовой нуклеопротеидный антиген – в цитоплазме
7
8.
ЭпидемиологияИсточник инфекции: носители (нос, зев, кожа) и
больные люди, эндогенная инфекция; реже
животные или инфицированные продукты
Пути передачи: воздушно-капельный, воздушнопылевой, пищевой (пищевые интоксикации),
возможен контактно-бытовой
8
9.
Основные инфекции человека, вызываемыепатогенными стрептококками
Вызывают:
• локальные (ангина, гайморит, кариес, отиты)
• генерализованные инфекции (ревматизм, рожа, скарлатина,
стрептодермии, сепсис, гломерулонефрит, пневмонии)
S. pyogenes (группа А), вызывает гнойно-воспалительные процессы
в, сопровождающиеся обильным гноеобразованием, а также
сепсис
S. agalactia (группа В), вызывает послеродовые и урогенитальные
инфекции, маститы и вагиниты у женщин, сепсис и менингиты у
новорожденных.
S. mutans, S. mitis, S. sanguis, S. salivarius (зеленящие стрептококки)
участвуют в формировании зубных бляшек
S.pneumoniae (пневмококки) вызывают пневмонию
9
10.
Бета-гемолитический стрептококк может привести кразвитию следующих заболеваний:
Ангина
Отит
Фарингит
Рожистое воспаление
Скарлатина
Менингит
Сепсис
Ревматизм
Гломерулонефрит
Бактерии выделяют
определенные токсины,
которые проникают в кровяное
русло и являются причиной
появления характерных
симптомов.
11.
12.
13.
14.
Микробиологическая диагностика• Цель: выделение и идентификация стрептококков
• Материал: гной, слизь из зева, соскоб с
пораженного участка кожи, мокрота, моча,кровь
• Основные методы исследования:
Микроскопический (мазок и окраска по Граму)
Микробиологический (изучение комплекса биологических
свойств)
14
15.
Микробиологическая диагностикастрептококков
1 день
1.
Ориентировочная бактериоскопия (окраска по Граму: пары или
цепочки грам(+) кокков)
2.
Посев на кровяной агар Колумбиа с целью получения изолированных
колоний
2 день
1.
Изучение культуральных свойств (мелкие бесцветные колонии с
зонами α-, ß- и γ-гемолиза);
2.
Приготовление мазка, окраска по Граму и изучение морфологических
и тинкториальных свойств: пары и цепочки грам(+) кокков
3.
Пересев на скошенный кровяной агар или сахарный бульон с целью
получения чистой культуры
15
16.
Микробиологическая диагностикастрептококков
3-4 день
1. Определение чистоты выделенной чистой культуры макроскопически и
микроскопически
2. Идентификация выделенной чистой культуры по
морфологическим и тинкториальным свойствам: пары и цепочки грам(+)
кокков
культуральным свойствам: мелкие бесцветные колонии с зонами α-, ß- и γгемолиза на кровяном агаре; придонно-пристеночный рост с образованием
зерен и хлопьев на сахарном бульоне, среда остается прозрачной;
биохимическим свойствам*: для полной оценки биохимических свойств
используют идентификационные тест-системы API 20 Strep
антигенным свойствам: реакция преципитации с полисахаридным
преципитиногеном С, выделенным из чистой культуры и сыворотками
серогрупп А, В, С и др.; затем определяют серовар в реакции латекс- или
коагглютинации.
16
3. Определение чувствительности выделенной чистой культуры
к
антибактериальным препаратам
17.
Лечение и профилактикаПрофилактика. Специфическая профилактика
стрептококковых инфекций не разработана.
Лечение проводится преимущественно
антибиотиками (пенициллины, цефалоспорины;
макролиды). Резистентность к ним развивается
медленно. Это дает возможность использовать
бета-лактамные антибиотики, в том числе
бензилпенициллин. Применяют
цефалоспорины, аминогликозиды, макролиды.
17
18.
Спасибо за внимание!Наши контакты:
117105, г. Москва, Варшавское шоссе, д. 16А
тел.: 8 (499)418-00-02 e-mail: mkramn@inbox.ru
www.mkramn.ru

medicine
medicine








